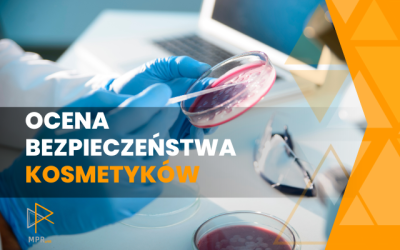

Newsletter 19.10.2023
 Evonik: nowa oferta filamentów PEEK dla technologii medycznejEvonik wprowadza pierwszy na świecie filament PEEK wzmocniony włóknem węglowym do długoterminowych implantów medycznych drukowanych w 3D. Filament o nazwie VESTAKEEP® z 12% lub 20% zawartością włókna węglowego powstał w celu łatwiejszej produkcji implantów. Wyrównanie włókna węglowego można kontrolować podczas procesu drukowania 3D. Idealna równowaga wysokiej wytrzymałości, plastyczności i niskiej masy sprawia, że PEEK jest niezawierającą metalu alternatywą dla implantów.
Evonik: nowa oferta filamentów PEEK dla technologii medycznejEvonik wprowadza pierwszy na świecie filament PEEK wzmocniony włóknem węglowym do długoterminowych implantów medycznych drukowanych w 3D. Filament o nazwie VESTAKEEP® z 12% lub 20% zawartością włókna węglowego powstał w celu łatwiejszej produkcji implantów. Wyrównanie włókna węglowego można kontrolować podczas procesu drukowania 3D. Idealna równowaga wysokiej wytrzymałości, plastyczności i niskiej masy sprawia, że PEEK jest niezawierającą metalu alternatywą dla implantów.
 Nie ma popytu, a jest import: problemy rynku recyklingu tworzyw sztucznychW ocenie Plastics Recyclers Europe, organizacji zrzeszającej europejskich recyklerów, niski popyt i wysoki import zagrażają europejskiemu przemysłowi recyklingu tworzyw sztucznych. Aby osiągnąć cele legislacyjne, niezbędne są mechanizmy egzekwowania prawa.
Nie ma popytu, a jest import: problemy rynku recyklingu tworzyw sztucznychW ocenie Plastics Recyclers Europe, organizacji zrzeszającej europejskich recyklerów, niski popyt i wysoki import zagrażają europejskiemu przemysłowi recyklingu tworzyw sztucznych. Aby osiągnąć cele legislacyjne, niezbędne są mechanizmy egzekwowania prawa.
 Przydatność opakowań produktów kosmetycznych do recyklinguRekopol Organizacja Odzysku Opakowań przygotował na zlecenie Polskiego Związku Przemysłu Kosmetycznego raport „Przydatność opakowań produktów kosmetycznych do recyklingu”.
Przydatność opakowań produktów kosmetycznych do recyklinguRekopol Organizacja Odzysku Opakowań przygotował na zlecenie Polskiego Związku Przemysłu Kosmetycznego raport „Przydatność opakowań produktów kosmetycznych do recyklingu”.
 BASF stawia na biotechnologię w produkcji środków ochrony roślinKoncern BASF zainwestuje ponad 10 mln euro w nową instalację do fermentacji biologicznych i biotechnologicznych środków ochrony roślin. Zakład w Ludwigshafen będzie wytwarzał produkty przynoszące wartość rolnikom, w tym biologiczne środki grzybobójcze i biologiczny zaprawiacz nasion. BASF planuje również wykorzystać tę fabrykę do produkcji głównego składnika Inscalis®, nowego środka owadobójczego pochodzącego ze szczepu grzybów.
BASF stawia na biotechnologię w produkcji środków ochrony roślinKoncern BASF zainwestuje ponad 10 mln euro w nową instalację do fermentacji biologicznych i biotechnologicznych środków ochrony roślin. Zakład w Ludwigshafen będzie wytwarzał produkty przynoszące wartość rolnikom, w tym biologiczne środki grzybobójcze i biologiczny zaprawiacz nasion. BASF planuje również wykorzystać tę fabrykę do produkcji głównego składnika Inscalis®, nowego środka owadobójczego pochodzącego ze szczepu grzybów.
REKLAMA
Laboratorium Chemii Budowlanej Efekt zaprasza do uczestnictwa w seminarium dot.: AKTUALNOŚCI W BRANŻY CHEMII BUDOWLANEJ przeznaczone dla Producentów, Kierowników Laboratoriów, Technologów oraz innych zainteresowanych pracowników branży budowlanej.
Seminarium odbędzie się w dniach 23-24 LISTOPADA 2023 w Hotelu Wodnik, Słok k/Bełchatowa
Priorytetowa tematyka obejmuje
- Zmiany w rozporządzeniu CPR, deklaracja środowiskowa
- Wpływ surowców na wyniki badań – spoiwa, zagęstniki, włókna
- Bezpieczeństwo pożarowe EITCS oraz innych wyrobów budowlanych
- Powłoki termorefleksyjne
Zgłoszenie odbywa się poprzez wypełnienie do dnia 20 października 2023 roku Karty Zgłoszeniowej i przesłanie jej na podany poniżej adres e-mailowy: kwalusiak@op.pl
Zaproszenie, plan seminarium oraz kartę zgłoszenia można pobrać na stronie internetowej w zakładce do pobrania.
https://www.efekt-zabrze.pl/do-pobrania/
 Energop trafia do Grupy OrlenOrlen Projekt podpisał z Agencją Rozwoju Przemysłu ostateczną umowę kupna ponad 74% udziałów spółki Energop. Transakcja zwiększy potencjał Grupy Orlen w zakresie realizacji inwestycji przemysłowych, w których ważnym elementem są zaawansowane technologicznie rurociągi.
Energop trafia do Grupy OrlenOrlen Projekt podpisał z Agencją Rozwoju Przemysłu ostateczną umowę kupna ponad 74% udziałów spółki Energop. Transakcja zwiększy potencjał Grupy Orlen w zakresie realizacji inwestycji przemysłowych, w których ważnym elementem są zaawansowane technologicznie rurociągi.
 Prawo unijne zagraża przemysłowi opakowań z tworzyw sztucznychLiczne europejskie organizacje branżowe działające w obszarze tworzyw sztucznych i opakowań przekonują, iż łańcuch wartości opakowań z tworzyw sztucznych wymaga odpowiedniej polityki opartej na podstawach naukowych i neutralności. Ma to zapewnić konkurencyjność europejskiego przemysłu opakowań z tworzyw sztucznych i wspierać osiągnięcie przez niego unijnych celów na rok 2050 w temacie zerowej emisji netto i obiegu zamkniętego.
Prawo unijne zagraża przemysłowi opakowań z tworzyw sztucznychLiczne europejskie organizacje branżowe działające w obszarze tworzyw sztucznych i opakowań przekonują, iż łańcuch wartości opakowań z tworzyw sztucznych wymaga odpowiedniej polityki opartej na podstawach naukowych i neutralności. Ma to zapewnić konkurencyjność europejskiego przemysłu opakowań z tworzyw sztucznych i wspierać osiągnięcie przez niego unijnych celów na rok 2050 w temacie zerowej emisji netto i obiegu zamkniętego.
 Ważne inwestycje w Grupie Azoty FosforyGrupa Azoty Fosfory dąży do zwiększenia efektywności energetycznej swojej produkcji. Dzięki planowanej modernizacji instalacji do produkcji kwasu siarkowego wraz z turbiną do produkcji energetycznej, ograniczy poziom emisji gazów cieplarnianych o około 20 000 MgCO2/rok. Koszt inwestycji to blisko 100 mln zł. Równolegle z wdrożeniem nowego projektu oddaje do użytku suszarnię obrotową wraz z nową komorą spalania na gaz ziemny, dzięki czemu zmniejszy się emisja dwutlenku węgla i dwutlenku siarki oraz ograniczona zostanie ilość przestojów technologicznych. Poza realizowanymi i wdrażanymi inwestycjami, Grupa Azoty prowadzi prace badawczo-rozwojowe w przedmiocie zagospodarowania fosfogipsu.
Ważne inwestycje w Grupie Azoty FosforyGrupa Azoty Fosfory dąży do zwiększenia efektywności energetycznej swojej produkcji. Dzięki planowanej modernizacji instalacji do produkcji kwasu siarkowego wraz z turbiną do produkcji energetycznej, ograniczy poziom emisji gazów cieplarnianych o około 20 000 MgCO2/rok. Koszt inwestycji to blisko 100 mln zł. Równolegle z wdrożeniem nowego projektu oddaje do użytku suszarnię obrotową wraz z nową komorą spalania na gaz ziemny, dzięki czemu zmniejszy się emisja dwutlenku węgla i dwutlenku siarki oraz ograniczona zostanie ilość przestojów technologicznych. Poza realizowanymi i wdrażanymi inwestycjami, Grupa Azoty prowadzi prace badawczo-rozwojowe w przedmiocie zagospodarowania fosfogipsu.
REKLAMA
SZKOLENIE ONLINE: Przewóz w sztukach przesyłki materiałów ciekłych zapalnych, zagrażających środowisku oraz aerozoli w transporcie drogowym (ADR) i morskim (IMDG)
Zapraszamy na szkolenie Przewóz w sztukach przesyłki materiałów ciekłych zapalnych, zagrażających środowisku oraz aerozoli w transporcie drogowym (ADR) i morskim (IMDG) mające na celu przedstawienie aspektów prawnych dotyczących ich bezpiecznego transportu. Wiele firm niestety nie ma świadomości, że takie produkty mogą stanowić materiał niebezpieczny w transporcie, a co za tym idzie powinny spełniać kryteria klasyfikacyjne ADR. Szkolenie skierowane jest w szczególności do firm produkujących lub prowadzących dystrybucję takich produktów.
Na szkoleniu zostaną przybliżone zagadnienia dotyczące sposobów pakowania, oznakowania, stosowania wyłączeń oraz wymaganej dokumentacji przy organizowaniu wysyłek takich produktów zarówno drogą lądową (ADR) jak i morską (IMDG). Omówione zostaną ponadto obowiązki przedsiębiorstw w odniesieniu do przepisów międzynarodowych jak i krajowych w tym obowiązku szkolenia pracowników, wyznaczenia doradcy ADR, składania rocznych sprawozdań z działalności.
Jeżeli są Państwo producentem, importerem lub dystrybutorem produktów ciekłych zapalnych, zagrażających środowisku lub aerozoli to są Państwo zobowiązani do spełnienia wielu wymagań oraz wypełnienia wielu obowiązków związanych z wprowadzeniem takich produktów na rynek.
Kalendarz szkoleń>>>
 Polski Pakt Plastikowy: ograniczenie opakowań nadmiernych i problematycznych przynosi korzyściPolski Pakt Plastikowy zachęca do podejmowania działań na rzecz identyfikacji i eliminacji tzw. opakowań nadmiernych i problematycznych z tworzyw sztucznych poprzez przeprojektowanie, innowacje i alternatywne modele dostawy.
Polski Pakt Plastikowy: ograniczenie opakowań nadmiernych i problematycznych przynosi korzyściPolski Pakt Plastikowy zachęca do podejmowania działań na rzecz identyfikacji i eliminacji tzw. opakowań nadmiernych i problematycznych z tworzyw sztucznych poprzez przeprojektowanie, innowacje i alternatywne modele dostawy.
 Uniejów gromadzi uczestników Forum Inteligentnego Rozwoju19-20 października 2023 r. w Uniejowie spotykają się uczestnicy Forum Inteligentnego Rozwoju.
Uniejów gromadzi uczestników Forum Inteligentnego Rozwoju19-20 października 2023 r. w Uniejowie spotykają się uczestnicy Forum Inteligentnego Rozwoju.
 Rafineria Gdańska wdraża Program Poprawy EfektywnościProgram Poprawy Efektywności to nowa inicjatywa w Rafinerii Gdańskiej, w ramach której można zgłosić projekty służące poprawie efektywności w różnych obszarach, nie tylko efektywności energetycznej. Głównymi celami są poprawa kosztów, identyfikacja i wdrażanie nowych projektów czy pomysłów. Poprawa efektywności to nie tylko optymalizacja pracy czy wymiana w obszarze urządzeń i maszyn.
Rafineria Gdańska wdraża Program Poprawy EfektywnościProgram Poprawy Efektywności to nowa inicjatywa w Rafinerii Gdańskiej, w ramach której można zgłosić projekty służące poprawie efektywności w różnych obszarach, nie tylko efektywności energetycznej. Głównymi celami są poprawa kosztów, identyfikacja i wdrażanie nowych projektów czy pomysłów. Poprawa efektywności to nie tylko optymalizacja pracy czy wymiana w obszarze urządzeń i maszyn.
REKLAMA
Weź udział w najważniejszym spotkaniu branży profesjonalnego utrzymania czystości w Polsce!
Targom CLEANING EXPO 2023 towarzyszyć będzie niezwykła energia bezpośrednich relacji, ekspozycja liderów branży, gwar biznesowych rozmów oraz inspirujący program wydarzeń:
- Dwudniowa konferencja Cleaning Forum,
- Prelekcje Polskiego Stowarzyszenia Firm Sprzątających,
- Wyścigi autonomicznych robotów sprzątających oraz zastosowanie innowacyjnych rozwiązań cyfrowych w usługach sprzątania,
- Profesjonalne pokazy czyszczenia posadzek oraz łazienek,
- Konsultacje ze specjalistami na stoiskach wystawców.
PROFESJONALIŚCI Z BRANŻY UTRZYMANIA CZYSTOŚCI WCHODZĄ BEZPŁATNIE PO REJESTRACJI!
CLEANING EXPO
24-25.10.2023
📍 Międzynarodowe Targi Poznańskie
https://cleaningexpo.pl/pl/aktualnosci/liderzy-zapraszaja-na-targi-cleaning-expo-2023/
 Nurt „Zero Waste” w kosmetyce, czyli porozmawiajmy o odpadachPowszechnie wiadomo, że nadmierna eksploatacja zasobów naturalnych w połączeniu z ogromną ilością wytwarzanych odpadów wywiera szkodliwy wpływ na naszą planetę. Wiele gałęzi przemysłu, między innymi branża kosmetyczna i higieny osobistej, działa zgodnie z liniowym modelem ekonomicznym opierającym się na schemacie „weź – wyprodukuj – wyrzuć”. W obecnej rzeczywistości należy jednak dążyć do ograniczania szkodliwego oddziaływania na środowisko, koncentrując wysiłki na modelu cyrkularnym, który obejmuje zapobieganie powstawaniu odpadów, ograniczanie ich ilości oraz ponowne wykorzystywanie.
Nurt „Zero Waste” w kosmetyce, czyli porozmawiajmy o odpadachPowszechnie wiadomo, że nadmierna eksploatacja zasobów naturalnych w połączeniu z ogromną ilością wytwarzanych odpadów wywiera szkodliwy wpływ na naszą planetę. Wiele gałęzi przemysłu, między innymi branża kosmetyczna i higieny osobistej, działa zgodnie z liniowym modelem ekonomicznym opierającym się na schemacie „weź – wyprodukuj – wyrzuć”. W obecnej rzeczywistości należy jednak dążyć do ograniczania szkodliwego oddziaływania na środowisko, koncentrując wysiłki na modelu cyrkularnym, który obejmuje zapobieganie powstawaniu odpadów, ograniczanie ich ilości oraz ponowne wykorzystywanie.
MPR Labs: Ocena bezpieczeństwa kosmetykuOcena bezpieczeństwa kosmetyku jest często kojarzona z Raportem Oceny Bezpieczeństwa Produktu Kosmetycznego (ang. Cosmetic Product Safety Report). Jest to kierunek jak najbardziej słuszny, jednak na ocenę czy produkt nie zagraża życiu i zdrowiu ludzi składa się wiele czynników – przede wszystkim tych z zakresu mikrobiologii.
MPR Labs: Ocena bezpieczeństwa kosmetykuOcena bezpieczeństwa kosmetyku jest często kojarzona z Raportem Oceny Bezpieczeństwa Produktu Kosmetycznego (ang. Cosmetic Product Safety Report). Jest to kierunek jak najbardziej słuszny, jednak na ocenę czy produkt nie zagraża życiu i zdrowiu ludzi składa się wiele czynników – przede wszystkim tych z zakresu mikrobiologii.
